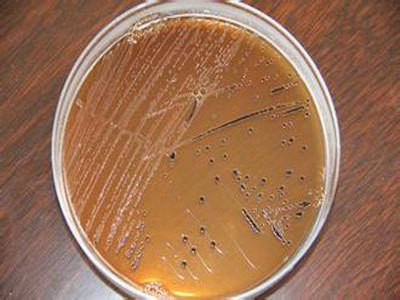

细菌也能助抗癌一臂之力?美国加州大学圣迭戈分校的研究小组称,他们对一种细菌进行改造,使其能够对抗癌药物提供指引,实现给药效率的最大化。疗效已经在 小鼠实验中得到了证实。相关论文在线发表在《自然》杂志网站上。目前,科学家对将细菌改造为活体治疗剂的兴趣愈发浓厚,但宿主反应和这一系统的长期有效性仍然有待评估。
新研究中,加州大学圣迭戈分校的杰夫·海斯迪与他的同事们用合成生物学方法对细菌的基因回路进行改造。经过改造的基因回路能控制一种肿瘤靶向性沙门氏菌的药物释放,通过周期性同步的细胞裂解使给药效率实现最大化。此外,该疗法还能通过细胞解体的方式控制细菌数量。
为了实现上述目的,研究人员首先对小鼠结直肠肿瘤的细菌种群动态进行了跟踪。然后,他们让结直肠癌小鼠口服菌株,其中一些单独服用,另一些与临床化疗药物一同服用。结果发现,经过回路改造的细菌与化疗的组合能减少癌细胞活动,相比只使用其中一种疗法的小鼠,使用组合疗法的小鼠生存时间更长。
研究人员称,他们的方法或许能利用一些在人体病灶区域生长的细菌为相关疾病的治疗带来新思路,借助合成生物学工具,催生出新的癌症疗法。
不过,在细菌被用作有效的抗癌疗法前还需进一步研究。美国约翰霍普金斯大学医学院的周世斌(音译)在同期发表在《自然》杂志上的另一篇评论文章中表示,虽然存在上述特性,但到目前为止,无论是否经过改造,单凭细菌本身还不太可能清除肿瘤。